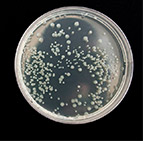
curso de kinesiología

Fechas
Días: 17 y 31 de mayo de 2019.
Duración y Horario
Duración: 4 + 4 horas.
Horario: 2 viernes, de 17 a 21 horas.
Profesor
Las Técnicas de refinamiento en Kinesiología tienen el objetivo de que el alumno profundice y refine las técnicas básicas que ha aprendido durante su primer ciclo de formación. Se trata de un curso avanzado de Kinesiología muy práctico y útil.
Hemos pensado que estas técnicas de refinamiento en kinesiología se materialicen en una serie de seminarios específicos para poder preguntar y corregir esos casos especialmente complejos que no responden como sería deseable.
De esta manera, propondremos durante diferentes viernes una serie de técnicas a aprender que permitan descubrir esa información primaria y que nos guíen cada vez con más seguridad y acierto a la fuente del problema (proceso).
Nuestra propuesta en este curso avanzado de Kinesiología.
Empezaremos con una primera propuesta de técnicas complementarias impartidas durante dos viernes diferentes. Aunque son complementarias no es obligatorio apuntarse a los dos días, se pueden seguir de manera independiente. No obstante, si alguna técnica no se alcanza a dar el primer viernes se dará en el siguiente.
Las clases se dividirán en un 60% de contenido teórico y un 40% de prácticas. Además, se trabajará con un paciente real el segundo viernes para ver la aplicación directa con el paciente.
Programa del viernes 17 de mayo
- Nueva técnica de subluxación y pies.
- Cuatro nuevos modos de andar.
- Patrón de anteriorización vertebral.
- Subluxación intraósea.
- TMT técnica ampliada.
Programa del viernes 31 de mayo
- Reflejos espinales viscerales biomagnéticos.
- Tetrógrado linfático.
- Ptosis de útero y pierna corta.
- Corazón desintegrado.
- Inhibición autogénica en casos emocionales.
- Test emocional con signos.
- Clínica.
CURSO DE KINESIOLOGÍA BÁSICA
Entra en contacto con esta poderosa herramienta terapéutica
Artículos de interés.
¿Tienes dudas, preguntas…?
Estaremos encantados de atenderte y asesorarte.